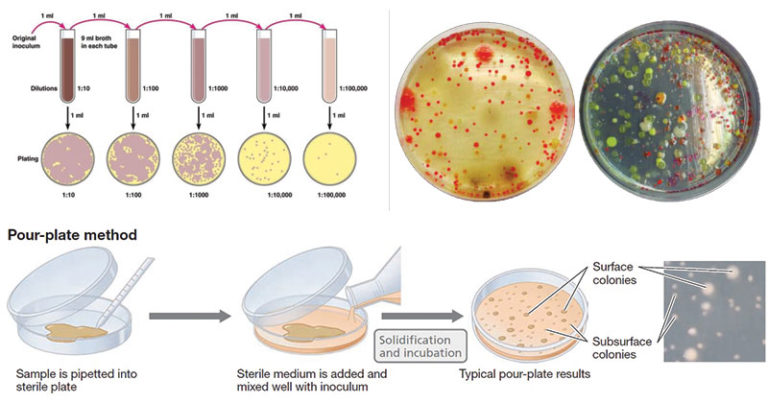
Perbedaan isolasi bakteri secara pour plate, streak plate, spread plate

Perbedaan isolasi bakteri secara pour plate, streak plate, spread plate
Metode dan Teknik Isolasi Mikroba – Generasi Biologi
Cara Streak Suspensi Bakteri Pada Media Plate — ATLM
Teknik Isolasi Bakteri
Dalam dunia ilmiah, para peneliti sering kali melakukan isolasi bakteri untuk mempelajari sifat-sifat mereka dan mengidentifikasi jenis-jenisnya. Isolasi bakteri merupakan proses pemisahan dan pemurnian bakteri dari lingkungan baik yang alami maupun yang dihasilkan oleh manusia. Proses ini penting untuk mempelajari dan memahami peran bakteri dalam berbagai aspek kehidupan.
1. Apa Itu Isolasi Bakteri?
Isolasi bakteri merupakan proses pemisahan dan pemurnian bakteri dari sampel lingkungan tertentu. Sampel tersebut bisa berupa tanah, air, makanan, atau bahan biologis lainnya. Proses isolasi dilakukan dengan tujuan untuk mengidentifikasi dan mengkarakterisasi jenis-jenis bakteri yang ada dalam sampel tersebut.
Isolasi bakteri dilakukan dengan langkah-langkah tertentu, yang umumnya melibatkan penanaman sampel dalam media pertumbuhan yang sesuai. Setelah bakteri tumbuh dalam media tersebut, maka bakteri-bakteri tersebut dapat diisolasi dan dipisahkan menjadi koloni-koloni individu. Koloni-koloni ini kemudian dapat dianalisis lebih lanjut untuk mengidentifikasi jenis dan sifat-sifat bakteri yang ada.
2. Ciri-ciri Bakteri
Bakteri adalah organisme mikroskopis yang umumnya memiliki ukuran sekitar 1 hingga 10 mikrometer. Mereka bisa memiliki berbagai bentuk dan struktur, seperti batang, bola, atau spiral. Beberapa ciri-ciri umum bakteri adalah:
- Uniseluler: Bakteri terdiri dari satu sel yang lengkap dengan semua komponennya, seperti membran sel, DNA, dan organel-organel sel.
- Prokariotik: Bakteri adalah organisme prokariotik, yang berarti mereka tidak memiliki inti sel.
- Multiselularitas: Beberapa bakteri dapat membentuk koloni-koloni, di mana sejumlah sel bakteri hidup bersama dan saling berinteraksi.
- Proliferasi cepat: Bakteri memiliki kemampuan untuk berkembang biak dengan cepat, dengan waktu replikasi yang sangat singkat.
- Adaptabilitas tinggi: Bakteri memiliki kemampuan untuk beradaptasi dengan berbagai lingkungan, termasuk yang ekstrim seperti suhu tinggi atau rendah, pH yang asam atau basa, dan ketersediaan nutrisi yang terbatas.
- Variasi genetik: Bakteri memiliki kemampuan untuk berganti-ganti genetik (mutasi) dan bertukar material genetik dengan bakteri lain (rekombinasi genetik).
3. Klasifikasi Bakteri
Klasifikasi bakteri adalah proses pengelompokkan bakteri berdasarkan karakteristik dan sifat-sifat yang dimilikinya. Klasifikasi ini penting agar kita dapat memahami keragaman bakteri yang ada di alam dan menjelaskan hubungan evolusioner antara berbagai jenis bakteri.
Bakteri dikelompokkan ke dalam berbagai taksonomi, termasuk:
- Divisi bakteri: Bakteri dibagi menjadi beberapa divisi utama, seperti Firmicutes, Proteobacteria, Actinobacteria, dan Cyanobacteria.
- Kelas: Divisi bakteri dibagi menjadi kelas-kelas yang lebih spesifik, seperti Gammaproteobacteria, Alphaproteobacteria, dan Betaproteobacteria.
- Ordo: Kelas bakteri dibagi menjadi ordo-ordo yang lebih spesifik, seperti Enterobacteriales, Lactobacillales, dan Pseudomonadales.
- Famili: Ordo bakteri dibagi menjadi famili-famili yang lebih spesifik, seperti Enterobacteriaceae, Lactobacillaceae, dan Pseudomonadaceae.
- Genus: Famili bakteri dibagi menjadi genus-genus yang lebih spesifik, seperti Escherichia, Lactobacillus, dan Pseudomonas.
- Spesies: Genus bakteri dibagi menjadi spesies-spesies yang lebih spesifik, seperti Escherichia coli, Lactobacillus acidophilus, dan Pseudomonas aeruginosa.
4. Jenis-jenis Bakteri
Terdapat ribuan jenis bakteri yang telah diidentifikasi dan diklasifikasikan oleh ilmuwan. Beberapa jenis bakteri yang umum ditemukan di alam meliputi:
- Bakteri aerob: Bakteri yang membutuhkan oksigen untuk melakukan respirasi.
- Bakteri anaerob: Bakteri yang tidak membutuhkan oksigen untuk melakukan respirasi.
- Bakteri fototrofik: Bakteri yang menggunakan energi cahaya untuk melakukan fotosintesis.
- Bakteri heterotrofik: Bakteri yang mendapatkan energi dari bahan organik.
- Bakteri autotrofik: Bakteri yang dapat menghasilkan energi sendiri dari bahan anorganik, seperti karbon dioksida dan mineral.
- Bakteri patogen: Bakteri yang dapat menyebabkan penyakit pada manusia dan hewan.
- Bakteri probiotik: Bakteri yang memberikan manfaat bagi kesehatan manusia dan hewan.
5. Cara Berkembang Biak Bakteri
Bakteri memiliki kemampuan untuk berkembang biak dengan cepat. Mereka menghasilkan keturunan melalui beberapa cara, antara lain:
- Pembelahan biner: Bakteri dapat membelah diri menjadi dua individu yang identik secara genetik.
- Konjugasi: Bakteri dapat bertukar material genetik dengan bakteri lain melalui kontak langsung.
- Transduksi: Gen-gen bakteri dapat ditransfer melalui virus bakteriofag.
- Transformasi: Bakteri dapat mengambil DNA dari lingkungan dan menggabungkannya ke dalam genom mereka sendiri.
- Pembentukan spora: Beberapa jenis bakteri membentuk spora untuk bertahan dalam kondisi lingkungan yang buruk.
6. Contoh Isolasi Bakteri
Isolasi bakteri dilakukan dalam berbagai situasi dan tujuan penelitian. Sebagai contoh, isolasi bakteri dapat dilakukan untuk:
- Mendeteksi keberadaan bakteri patogen dalam makanan atau air.
- Mengisolasi bakteri probiotik untuk penggunaan dalam produk makanan atau suplemen.
- Memisahkan dan mengidentifikasi spesies bakteri tertentu dalam sampel lingkungan tertentu.
- Memonitor populasi bakteri dalam suatu ekosistem alami.
- Mengkarakterisasi sifat-sifat metabolik atau resistensi antibiotik bakteri tertentu.
7. Kesimpulan
Isolasi bakteri merupakan proses penting dalam ilmu mikrobiologi untuk mempelajari dan memahami jenis-jenis dan sifat-sifat bakteri. Dengan memahami karakteristik dan perilaku bakteri, kita dapat mengembangkan strategi dan teknologi baru untuk mengendalikan penyakit, memperbaiki lingkungan, dan meningkatkan kualitas hidup manusia.
Perbedaan isolasi bakteri secara pour plate, streak plate, spread plate.

Metode dan Teknik Isolasi Mikroba – Generasi Biologi.

Cara Streak Suspensi Bakteri Pada Media Plate — ATLM.
Teknik Isolasi Bakteri.
